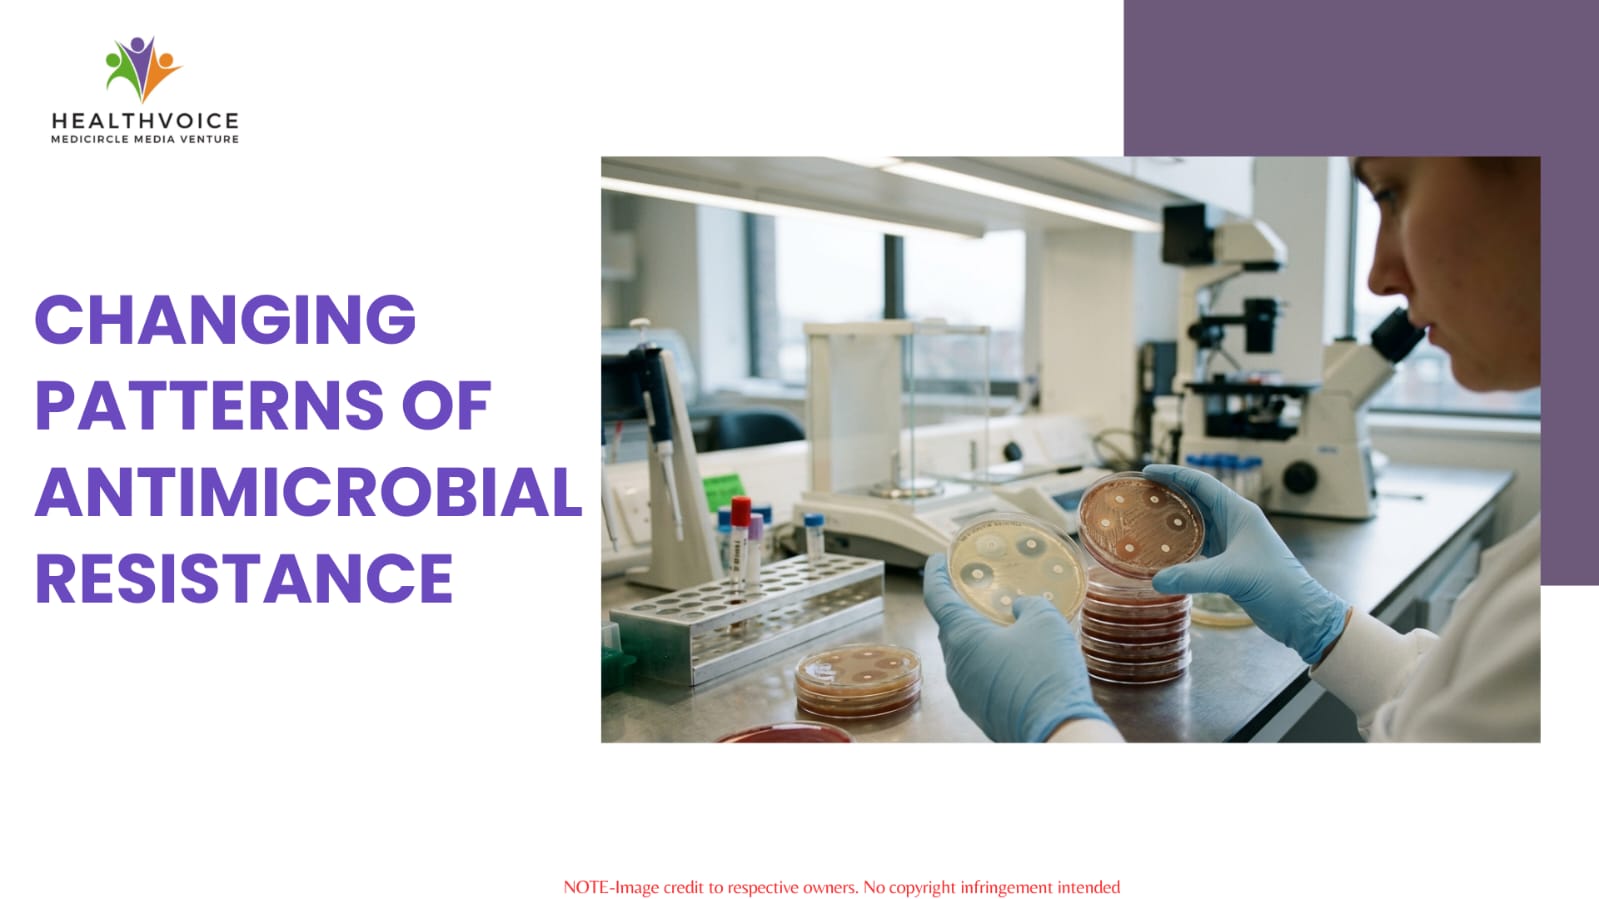

Antimicrobial resistance in India is making common infections harder to treat as bacteria evolve. By using antibiotics responsibly and improving hygiene, we can protect these vital medical tools.
Rising Antimicrobial Resistance
For many decades, people in India have lived in an era where a simple visit to a clinic for antibiotics could fix almost any infection. These medications were once the strongest shield available against disease. However, that protective shield is now becoming thin. Across the country, the way bacteria respond to medical treatment is changing in a way that health experts find very worrying. Data from major organizations like the Indian Council of Medical Research shows that the germs causing common illnesses are no longer the same. They have adapted to survive the very medications that were created to eliminate them.
This situation is known as Antimicrobial Resistance. It is often called a hidden crisis. It does not always make the news like a sudden outbreak of a virus would. Instead, it is slowly moving into our homes and local hospitals. In India, people often live in crowded areas and rely on quick remedies bought over the counter. These habits cause resistant patterns to grow faster. Common health issues such as chest infections or skin boils are now much more difficult to cure than they were only a few years ago.
From Simple to Stubborn
In the past, a doctor could prescribe a standard antibiotic with great confidence. These drugs were gentle but they were also effective. Today, the medical field is seeing a large drop in the success of these traditional treatments. For example, the bacteria known as E. coli is a frequent cause of urinary tract infections. It is now often resistant to drugs like ciprofloxacin, which used to be the primary choice for treatment.
There is even more concern regarding the failure of last resort medications. These are the powerful drugs kept for life threatening cases in intensive care units. When bacteria learn to defeat these final defenses, doctors must use older and more toxic drugs. These alternatives require constant watching and often lead to much longer stays in the hospital. What used to be a simple recovery has now turned into a complex medical struggle.
Why Resistance Spreads
The growth of these superbugs in India is not a random event. It is driven by specific cultural habits and systemic issues. One major reason is the ease of buying antibiotics without talking to a doctor first. Many individuals take these medications for viral infections like the common cold. Antibiotics are completely useless against viruses. This unnecessary use gives bacteria a chance to practice and learn how to resist the medicine.
Another serious problem is the habit of stopping a prescription too early. Many patients feel better after a couple of days and save the remaining pills for another time. This is a dangerous practice. It only kills the weak bacteria while the strongest ones survive to multiply. These survivors then share their resistance traits with other germs. Furthermore, the high use of antibiotics in farming means that resistant strains can enter our food and water. This makes the issue much larger than just what happens at a pharmacy.
Risks to Modern Surgery
The impact of these changing patterns is not limited to minor illnesses. It threatens the entire foundation of modern surgical care. Many procedures that are now considered routine depend on antibiotics to prevent infections. These include operations like C-sections or hip replacements. If the drugs used to protect a patient during an operation no longer work, the risk of the procedure increases significantly.
For the average citizen, this means that medical results are becoming harder to predict. A small infection that should have gone away in one week might now stay for much longer. It might require many different drugs and specialized laboratory tests. This shift is forcing medical professionals to stop guessing which medicine might work. They are moving toward precise testing to find the exact type of bacteria before they start any treatment.
Efforts for Better Health
The healthcare system in India is fighting back with a plan called Antibiotic Stewardship. This plan involves teaching doctors to be very careful about when they use antibiotics. By tracking these patterns using digital tools, health officials can see which drugs are failing. They can then change treatment rules to match the current situation.
There is also a growing strategy known as One Health. This approach looks at how the health of humans and animals is linked to the environment. By cleaning up waste near drug factories and reducing antibiotic use in cows or chickens, the country is trying to stop the cycle of resistance at the start.
Steps for Individuals
The problem seems very large, but individual actions are the best way to slow it down. We must treat antibiotics as a very precious resource.
By washing our hands and never using leftover pills from a friend, we can reduce the heavy pressure on our hospitals.
Common Questions
Why Refuse My Antibiotics?
Most fevers are caused by viruses. Antibiotics only work against bacteria. Taking them for a virus will not help you feel better and it helps bacteria become stronger.
Are Bacteria More Dangerous?
They are not always more aggressive, but they are much harder to eliminate. The danger comes from having fewer medicines available to stop the infection.
Is My Infection Resistant?
The most common sign is an illness that does not get better after several days of treatment. In these cases, a doctor will perform a sensitivity test to find a working drug.
Final Thoughts
The changing patterns of resistance in India show that the time of easy cures is ending. We cannot take our miracle drugs for granted anymore. This is a journey that requires doctors to prescribe with care and patients to use medicine with responsibility. Protecting our ability to fight disease is a major challenge for this generation. We must focus on better testing and high standards of cleanliness to keep these tools working for the future.
Team Healthvoice
#OneHealth #MedicalAwareness #healthvoice
